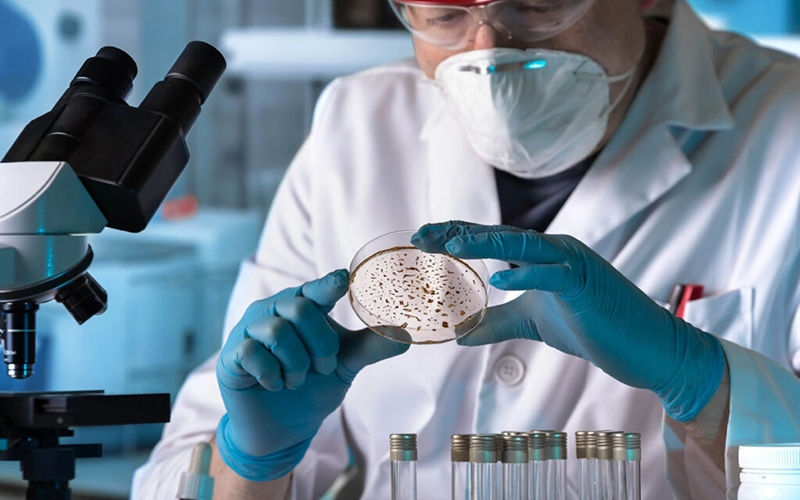
...

Bilgilendirme
Bulaşıcı Hastalık Önleme protokolü
Kızkalesi Sarı Konak Apart Otel’de hijyen, temizlik ve güvenli konaklama protokolleri ile ailece güvenli tatil imkanı
Devamını Oku
Kızkalesi Plajında Yapılabilir Spor Aktiviteleri
Kızkalesi’nde plaj sporları, su aktiviteleri ve eğlenceli sahil etkinlikleriyle dolu bir tatil deneyimi yaşayın. Spor, sağlık ve eğlenceyi bir arada keşfedin.
Devamını Oku
Kızkalesi’nde Yapmadan Dönmemeniz Gereken 10 Şey
Kızkalesi’nde mutlaka yapılması gereken 10 unutulmaz deneyimi keşfedin. Kale gezisi, plaj keyfi, lezzet durakları ve gizli koylar bu listede! Sarı Konak Apart Otel blogunda şimdi okuyun.
Devamını Oku
Kızkalesi’nde Turizmin Yolculuğu
Kızkalesi'nin tarihî geçmişi, turizmdeki gelişimi ve doğal güzellikleriyle nasıl Akdeniz’in gözde tatil beldesine dönüştüğünü öğrenin. Sarı Konak Apart Otel blogunda samimi bir keşif sizi bekliyor.
Devamını Oku
Kızkalesi’ne İlk Kez Gelenler İçin Mini Rehber
Mersin’in gözdesi Kızkalesi'nde tatil planlayanlar için kapsamlı bir rehber: Kızkalesi Plajı, tarihi Kızkalesi, yürüyüş rotaları ve Sarı Konak Apart Otel’de konforlu konaklama önerileri.
Devamını Oku
Çocuklar İçin Kızkalesi Sahilinde ve Deniz Kenarında Vakit Geçirmenin Sağlık Faydaları
Kızkalesi sahilinde çocuklarınızla vakit geçirmenin fiziksel, zihinsel ve duygusal sağlık üzerindeki etkilerini keşfedin. Aile dostu bir tatil için öneriler Sarı Konak Apart Otel blogunda.
Devamını Oku
Kızkalesi Plajında Güneşten Korunun !
kızkalesi plajında güneş ışınlarından korunma yolları..
Devamını Oku
Mavi Bayrak Nedir?
Kızkalesi Plajı, uluslararası Mavi Bayrak ödülüyle Akdeniz'in en temiz ve güvenli plajları arasında yer alıyor. Ailece huzurlu ve çevre dostu bir tatil için ideal!
Devamını Oku
Apart Otel Nedir ?
Apart otel ve apart pansiyon nedir? Avantajları, özellikleri ve seçim kriterleriyle ev konforunda tatil rehberi. Aileler ve gruplar için ideal konaklama modeli.
Devamını Oku